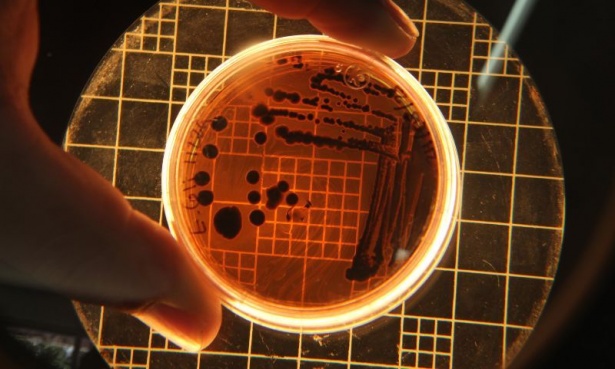

Скритата заплаха: Как ежедневни дейности поддържат смъртоносни болести
В продължение на десетилетия Китай води мащабна и последователна битка срещу смъртоносната паразитна инфекция шистозомиаза, постигайки значителен напредък в ограничаването й. Въпреки това в някои райони на страната заразата продължава да намира благоприятна среда. Проучване, ръководено от Училището по обществено здраве към Университета на Колорадо „Аншуц“, разкрива причините за тази устойчивост – от традиционните земеделски практики до рисковите санитарни условия – показвайки, че дори най-сериозните мерки за обществено здраве могат да бъдат подкопани от ежедневните дейности на хората.
Глобална заплаха за здравето
Шистозомиазата – паразитна инфекция, засягаща приблизително 200 милиона души по света – причинява анемия, умора, забавен растеж, увреждане на черния дроб и в някои случаи рак. Инфекцията се предава при обичайни селскостопански, битови, професионални и развлекателни дейности, свързани с контакт със заразена вода.
| » Мозъкоядна амеба е открита в питейната вода на два австралийски града |
Шистозомиазата е една от редица „пренебрегвани тропически болести“, които засягат най-вече бедните и селските общности без достъп до безопасна питейна вода и адекватна канализация. Няколко държави в Африка и Азия, сред които и Китай, работят активно за изкореняването на болестта. В тези райони обаче продължават да се появяват малки огнища на инфекцията, заплашвайки общественото здраве и националните програми за елиминиране.

„Дори когато общите нива на разпространение са ниски, болестта може да се задържи в някои среди, които наричаме горещи точки, което прави последния тласък за нейното елиминиране най-труден.“, коментира водещият автор на проучването д-р Елизабет Карлтън. „Нашето проучване е предназначено да разбере какво се случва в последния етап от елиминирането на болестта. Откритията ни подчертават, че разбирането на рисковите фактори в домакинствата и околната среда на локално ниво е ключово за защитата на населението и поддържането на постиженията в общественото здраве в световен мащаб.“
Рискови фактори при отделните домакинства
Проучването проследява села в Югозападен Китай в продължение на повече от десетилетие, за да разбере как рискът от шистозомиаза се променя с течение на времето. Изследователи от Съединените щати и Китай се фокусират върху малки населени места с активни огнища, където заразата остава устойчива въпреки усилията за ограничаването й.
Екипът комбинира традиционна теренна работа, включително домакински проучвания и оценки на околната среда, със съвременни методи, базирани на изкуствен интелект. С помощта на алгоритми с AI учените анализират хиляди данни, за да идентифицират предикторите за инфекция (маркери и рискови фактори, които предсказват появата или наличието на инфекциозен процес). Те също така проследяват как рискът постепенно се измества от ниво село към отделни домакинства.
Проучването установява, че в селата с обширни обработваеми площи, торени редовно с човешки отпадъци, и с лоши санитарни условия се отчита по-висока заболеваемост. С намаляването на броя на инфекциите факторите на ниво домакинство стават все по-значими с времето. Сред тях са площта на земята, която семейството обработва, наличието на съвременна тоалетна в дома и дори притежанието на котки и кучета, които могат да разпространяват паразита.

По-възрастните хора са най-засегнати
В хода на проучването учените наблюдават промяна във възрастовите групи, които са най-застрашени. В края на проследяването най-засегнати се оказват по-възрастните хора, което отразява демографските промени в селските райони.
„Стратегиите, насочени към цялата общност, са ефективни в първите етапи, но не са достатъчни за елиминиране на болестта.“, коментира Карлтън. „Целенасочените интервенции на ниво домакинство – като подобряване на санитарните условия, промяна на земеделските практики и наблюдение на домашните животни – са от ключово значение за завършване на процеса по елиминиране на болестта.“
Адаптиране на стратегии
За да се елиминира шистозомиазата, програмите за обществено здраве и политиците в Китай и други страни трябва да включват подробни данни за селското стопанство, санитарните условия и собствеността на домашни животни. По този начин ресурсите ще се използват по-целенасочено, рискът от повторна поява ще бъде ограничен, а процесът на елиминиране – ускорен.
„Елиминирането на болестта изисква адаптиране на стратегии и интегриране на данни за хора, животни и околната среда. Нашето проучване предоставя пътна карта за завършване на борбата с болестите, но са необходими действия.“, обяснява Карлтън.
- The hidden infections that refuse to go away: How household practices can stop deadly diseases: https://medicalxpress.com/news/2026-02-hidden-infections-household-deadly-diseases
- The hidden infections that refuse to go away: how household practices can stop deadly diseases: https://www.the-microbiologist.com/news/the-hidden-infections-that-refuse-to-go-away-how-household-practices-can-stop-deadly-diseases/8147.article










Коментари към Скритата заплаха: Как ежедневни дейности поддържат смъртоносни болести